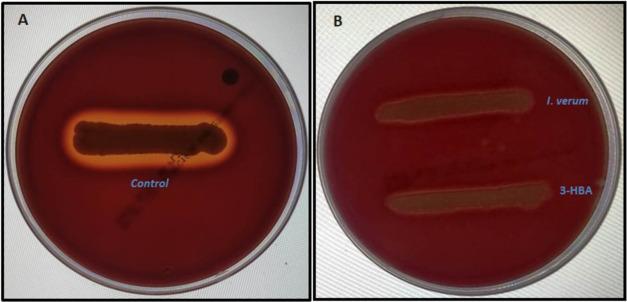
https://cdn.ncbi.nlm.nih.gov/pmc/blobs/0e39/9088959/96d1197376e2/ao1c07178_0007.jpg

源自[具体来源未提及]的3-羟基苯甲酸可抑制[具体细菌名称未提及]的生物膜相关Agr和Sar群体感应系统。
Biofilm-Associated Agr and Sar Quorum Sensing Systems of Are Inhibited by 3-Hydroxybenzoic Acid Derived from .
作者信息
Ganesh Pitchaipillai Sankar, Veena Krishnamurthy, Senthil Renganathan, Iswamy Koneti, Ponmalar Esaki Muthu, Mariappan Vanitha, Girija A S Smiline, Vadivelu Jamuna, Nagarajan Samuthira, Challabathula Dinakar, Shankar Esaki Muthu
机构信息
Department of Microbiology, Saveetha Dental College and Hospital, Saveetha Institute of Medical and Technical Sciences, Velappanchavadi, PH Road, Chennai 600077, Tamilnadu, India.
Infection Biology, Department of Life Sciences, Central University of Tamil Nadu, Neelakudi, Tiruvarur 610005, Tamilnadu, India.
出版信息
ACS Omega. 2022 Apr 20;7(17):14653-14665. doi: 10.1021/acsomega.1c07178. eCollection 2022 May 3.
Biofilm-producing () is less sensitive to conventional antibiotics than free-living planktonic cells. Here, we evaluated the antibiofilm activity of () and one of its constituent compounds 3-hydroxybenzoic acid (3-HBA) against multi-drug-resistant . We performed gas chromatography-mass spectroscopy (GC-MS) to identify the major constituents in the methanolic extract of . Ligand-receptor interactions were studied by molecular docking, and investigations were performed using crystal violet assay, spreading assay, hemolysis, proteolytic activity, and growth curve analysis. The methanolic extract of inhibited at 4.8 mg/mL, and GC-MS analysis revealed anethole, m-methoxybenzaldehyde, and 3-HBA as the major constituents. Molecular docking attributed the antibiofilm activity to an active ligand present in 3-HBA, which strongly interacted with the active site residues of AgrA and SarA of . At a subinhibitory concentration of 2.4 mg/mL, the extract showed biofilm inhibition. Similarly, 3-HBA inhibited biofilm activity at 25 μg/mL (90.34%), 12.5 μg/mL (77.21%), and 6.25 μg/mL (62.69%) concentrations. Marked attrition in bacterial spreading was observed at 2.4 mg/mL (crude extract) and 25 μg/mL (3-HBA) concentrations. The methanol extract of and 3-HBA markedly inhibited β-hemolytic and proteolytic activities of . At the lowest concentration, the extract (2.4 mg/mL) and 3-HBA (25 μg/mL) did not inhibit bacterial growth. Optical microscopy and SEM analysis confirmed that and 3-HBA significantly reduced biofilm dispersion without disturbing bacterial growth. Together, we found that the antibiofilm activity of and 3-HBA strongly targeted the Agr and Sar systems of .
产生物膜的()比自由生活的浮游细胞对传统抗生素更不敏感。在此,我们评估了()及其一种成分化合物3 - 羟基苯甲酸(3 - HBA)对多重耐药()的抗生物膜活性。我们进行了气相色谱 - 质谱联用(GC - MS)以鉴定()甲醇提取物中的主要成分。通过分子对接研究配体 - 受体相互作用,并使用结晶紫测定、扩散测定、溶血、蛋白水解活性和生长曲线分析进行()研究。()的甲醇提取物在4.8 mg/mL时抑制(),GC - MS分析显示茴香脑、间甲氧基苯甲醛和3 - HBA为主要成分。分子对接将抗生物膜活性归因于3 - HBA中存在的一种活性配体,其与()的AgrA和SarA的活性位点残基强烈相互作用。在2.4 mg/mL的亚抑制浓度下,提取物显示出生物膜抑制作用。同样,3 - HBA在25 μg/mL(90.34%)、12.5 μg/mL(77.21%)和6.25 μg/mL(62.69%)浓度下抑制生物膜活性。在2.4 mg/mL(粗提取物)和25 μg/mL(3 - HBA)浓度下观察到细菌扩散明显减少。()的甲醇提取物和3 - HBA显著抑制()的β - 溶血和蛋白水解活性。在最低浓度下,()提取物(2.4 mg/mL)和3 - HBA(25 μg/mL)不抑制细菌生长。光学显微镜和扫描电子显微镜分析证实,()和3 - HBA显著减少生物膜分散而不干扰细菌生长。总之,我们发现()和3 - HBA的抗生物膜活性强烈靶向()的Agr和Sar系统。